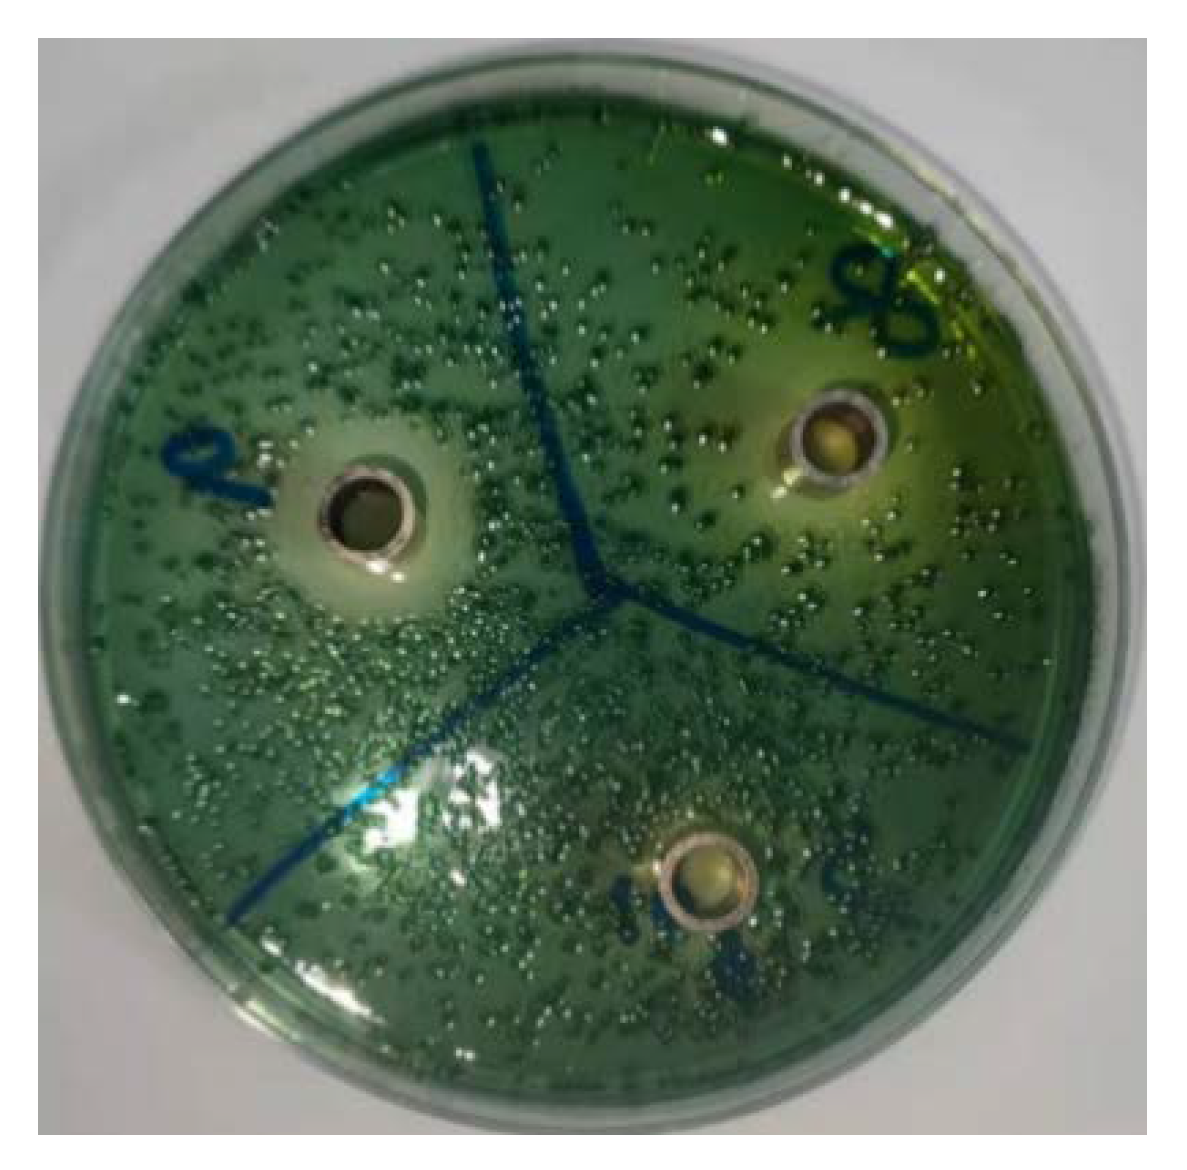

Combined Therapy of Probiotic Microcapsules and Bomidin in Vibrio parahaemolyticus–Infected Rats
Abstract
1. Introduction
2. Materials and Methods
2.1. Bacterial Strains and PCR Identification
2.2. Preparation of Microcapsules
2.3. Optimization of the Preparation Conditions
2.4. Tolerance Test of Microencapsulated Lacticaseibacillus casei CGMCC1.8727
2.5. In Vitro Test for Antibacterial Activity
2.6. In Vivo Test for Antibacterial Activity
2.7. Statistics
3. Results
3.1. Verification of Lacticaseibacillus casei CGMCC 1.8727
3.2. Morphology of Microencapsulated Lacticaseibacillus casei CGMCC1.8727
3.3. Single–Factor Tests
3.4. Orthogonal Test
3.5. Stability Tests
3.5.1. Stability of Lacticaseibacillus casei CGMCC1.8727 Microcapsules in Artificial Gastrointestinal Tract Environment
3.5.2. Stability of Microencapsulated Lacticaseibacillus casei CGMCC1.8727 during Storage
3.5.3. Oxford Cup Bacteriostasis Test for Lacticaseibacillus casei CGMCC1.8727
3.6. In Vitro Experiments
3.7. In Vivo Test Index Results and Analysis
3.7.1. Analysis of Mental State and Survival Curve of Rats
3.7.2. Analysis of Pathological Sections from Rat Duodenum
3.7.3. Changes in Inflammatory Factors in Duodenal Tissue Supernatant
3.7.4. Concentration Change and Colony Identification of Vibrio parahaemolyticus in Rat Faeces
3.8. Analysis of Macrogenomic Sequencing Results of Rat Faeces in Each Experimental Group
3.8.1. Effective Sequence Analysis
3.8.2. Alpha Diversity Analysis among Intestinal Microflora of Rats in Experimental Groups
3.8.3. Beta Diversity Analysis of Intestinal Microbiota of Rats in Experimental Groups
3.8.4. Changes in Composition and Structure of Rat Faecal Flora at the Phylum and Genus Level
4. Discussion
Author Contributions
Funding
Institutional Review Board Statement
Informed Consent Statement
Data Availability Statement
Conflicts of Interest
References
- Letchumanan, V.; Chan, K.G.; Lee, L.H. Vibrio parahaemolyticus: A review on the pathogenesis, prevalence, and advance molecular identification techniques. Front. Microbiol. 2014, 5, 705. [Google Scholar] [CrossRef] [PubMed]
- Li, Z.; Lu, W.; Jia, S.; Yuan, H.; Gao, L.H. Design and application of conjugated polymer nanomaterials for detection and inactivation of pathogenic microbes. ACS Appl. Bio Mater. 2020, 4, 370–386. [Google Scholar] [CrossRef] [PubMed]
- Krawczyk, B.; Wityk, P.; Gałęcka, M.; Michalik, M. The many faces of Enterococcus spp.—Commensal, probiotic and opportunistic pathogen. Microorganisms 2021, 9, 1900. [Google Scholar] [CrossRef] [PubMed]
- Zheng, J.; Wittouck, S.; Salvetti, E.; Franz, C.M.; Harris, H.M.; Mattarelli, P.; O’toole, P.W.; Pot, B.; Vandamme, P.; Walter, J.; et al. A taxonomic note on the genus lactobacillus: Description of 23 novel gene–ra, emended description of the genus lactobacillus beijerinck 1901, and union of lactobacillaceae and leuconostoca–ceae. Int. J. Syst. Evol. Microbiol. 2020, 70, 2782–2858. [Google Scholar] [CrossRef]
- Zhao, Y.M. A probiotic Composition Having an Anti–Sensitization Effect. Sichuan Province. CN111296842B, 5 January 2021. [Google Scholar]
- Ingrassia, I.; Leplingard, A.; Darfeuille–Michaud, A. Lactobacillus casei DN–114 001 inhibits the ability of adherent–invasive Escherichia coli isolated from Crohn’s disease patients to adhere to and to invade intestinal epithelial cells. Appl. Environ. Microbiol. 2005, 71, 2880–2887. [Google Scholar] [CrossRef]
- Lee, C.Y.; Yu, M.C.; Perng, W.T.; Lin, C.C.; Lee, M.Y.; Chang, Y.L.; Lai, Y.Y.; Lee, Y.C.; Kuan, Y.H.; Wei, J.C.C.; et al. No additional cholesterol–lowering effect observed in the combined treatment of red yeast rice and Lactobacillus casei in hyperlipidemic patients: A double–blind randomized controlled clinical trial. Chin. J. Integr. Med. 2017, 23, 581–588. [Google Scholar] [CrossRef]
- Zhang, Y.; Ma, C.; Zhao, J.; Xu, H.; Hou, Q.; Zhang, H. Lactobacillus casei Zhang and vitamin K2 prevent intestinal tumorigenesis in mice via adiponectin–elevated different signaling pathways. Oncotarget 2017, 8, 24719–24727. [Google Scholar] [CrossRef]
- Peng, W.; Talpur, M.Z.; Zeng, Y.; Xie, P.; Li, J.; Wang, S.; Wang, L.; Zhu, X.; Gao, P.; Jiang, Q.; et al. Influence of fermented feed additive on gut morphology, immune status, and microbiota in broilers. BMC Vet. Res. 2022, 18, 218. [Google Scholar] [CrossRef]
- Colombo, M.; Todorov, S.D.; Carvalho, A.F.; Nero, L.A. Technological properties of beneficial bacteria from the dairy environment and development of a fermented milk with the beneficial strain Lactobacillus casei MRUV6. J. Dairy Res. 2020, 87, 259–262. [Google Scholar] [CrossRef]
- Keshtmand, Z.; Akbaribazm, M.; Bagheri, Y.; Oliaei, R. The ameliorative effects of lactobacillus coagulans and Lacticaseibacillus casei probiotics on ccl4–induced testicular toxicity based on biochemical, histological and molecular analyses in rat. Andrologia 2021, 53, e13908. [Google Scholar] [CrossRef]
- Venema, K.; Verhoeven, J.; Beckman, C.; Keller, D. Survival of a probiotic–containing product using capsule–within–capsule technology in an in vitro model of the stomach and small intestine (TIM–1). Benef. Microbes 2020, 11, 403–409. [Google Scholar] [CrossRef] [PubMed]
- Nami, Y.; Kahieshesfandiari, M.; Lornezhad, G.; Kiani, A.; Elieh–Ali–Komi, D.; Jafari, M.; Jaymand, M.; Haghshenas, B. Administration of microencapsulated Enterococcus faecium ABRIINW. N7 with fructo–oligosaccharides and fenugreek on the mortality of tilapia challenged with Streptococcus agalactiae. Front. Vet. Sci. 2022, 9, 938380. [Google Scholar] [CrossRef]
- Jones, M.; Walker, D.; Ionescu, C.M.; Kovacevic, B.; Wagle, S.R.; Mooranian, A.; Brown, D.; Al–Salami, H. Microencapsulation of Coenzyme Q10 and bile acids using ionic gelation vibrational jet flow technology for oral delivery. Ther. Deliv. 2020, 11, 791–805. [Google Scholar] [CrossRef] [PubMed]
- Calderón–Oliver, M.; Ponce–Alquicira, E. The Role of Microencapsulation in Food Application. Molecules 2022, 27, 1499. [Google Scholar] [CrossRef] [PubMed]
- Eratte, D.; Dowling, K.; Barrow, C.J.; Adhikari, B.P. In–vitro digestion of probiotic bacteria and omega–3 oil co–microencapsulated in whey protein isolate–gum Arabic complex coacervates. Food Chem. 2017, 227, 129–136. [Google Scholar] [CrossRef]
- Song, C.; Wen, R.; Zhou, J.; Zeng, X.; Kou, Z.; Zhang, J.; Wang, T.; Chang, P.; Lv, Y.; Wu, R. Antibacterial and Antifungal Properties of a Novel Antimicrobial Peptide GK–19 and Its Application in Skin and Soft Tissue Infections Induced by MRSA or Candida albicans. Pharmaceutics 2022, 14, 1937. [Google Scholar] [CrossRef] [PubMed]
- Wang, C.; Hong, T.; Cui, P.; Wang, J.; Xia, J. Antimicrobial peptides towards clinical application: Delivery and formulation. Adv. Drug Deliv. Rev. 2021, 175, 113818. [Google Scholar] [CrossRef]
- Vanzolini, T.; Bruschi, M.; Rinaldi, A.C.; Magnani, M.; Fraternale, A. Multitalented synthetic antimicrobial peptides and their antibacterial, antifungal and antiviral mechanisms. Int. J. Mol. Sci. 2022, 23, 545. [Google Scholar] [CrossRef]
- Zhang, M. Mechanism of Action of Antimicrobial Peptide Bomidin and Its Application in the Culture of Macrobrachium rosenbergii. Master’s thesis, Nanjing Agricultural University, Nanjing, China, 2020. (In Chinese). [Google Scholar]
- Taveira, G.B.; de Oliveira Mello, É.; Simão, T.L.B.V.; Cherene, M.B.; de Oliveira Carvalho, A.; Muzitano, M.F.; Lassounskaia, E.; Pireda, S.; de Castro Miguel, E.; Basso, L.G.M.; et al. A new bioinspired peptide on defensin from C. annuum fruits: Antimicrobial activity, mechanisms of action and therapeutical potential. Biochim. Et Biophys. Acta (BBA)–Gen. Subj. 2022, 1866, 130218. [Google Scholar] [CrossRef]
- Song, Y.J. Preparation and Application of Chitosan/Xanthan Gum Probiotics Microcapsules. Master’s thesis, Shaanxi University of Science and Technology, Xi’an, China, 2015. (In Chinese). [Google Scholar]
- Feng, D.; Zhang, R.; Zhang, M.; Fang, A.; Shi, F. Synthesis of Eco–Friendly Silver Nanoparticles Using Glycyrrhizin and Evaluation of Their Antibacterial Ability. Nanomaterials 2022, 12, 2636. [Google Scholar] [CrossRef]
- Cortes, H.; Caballero–Florán, I.H.; Mendoza–Muñoz, N.; Escutia–Guadarrama, L.; Figueroa–González, G.; Reyes–Hernández, O.D.; González–Del Carmen, M.; Varela–Cardoso, M.; González–Torres, M.; Florán, B.; et al. Xanthan gum in drug release. Cell. Mol. Biol. 2020, 66, 199–207. [Google Scholar] [CrossRef] [PubMed]
- Choi, J.H.; Lee, W.; Song, C.; Moon, B.K.; Yoon, S.J.; Neves, N.M.; Reis, R.L.; Khang, G. Application of gellan gum–based scaffold for regenerative medicine. Bioinspired Biomater. 2020, 1249, 15–37. [Google Scholar]
- Choińska–Pulit, A.; Mituła, P.; Śliwka, P.; Łaba, W.; Skaradzińska, A. Bacteriophage encapsulation: Trends and potential applications. Trends Food Sci. Technol. 2015, 45, 212–221. [Google Scholar] [CrossRef]
- Zhao, H.X.; Li, Y.B. Application of microcapsule embedding technology in probiotic products. Dairy Sci. Technol. 2007, 6, 271–273. [Google Scholar]
- Tiani, K.A.; Yeung, T.W.; McClements, D.J.; Sela, D.A. Extending viability of Lactobacillus plantarum and Lactobacillus johnsonii by microencapsulation in alginate microgels. Int. J. Food Sci. Nutr. 2018, 69, 155–164. [Google Scholar] [CrossRef] [PubMed]
- Lai, K.; How, Y.; Pui, L. Microencapsulation of Lactobacillus rhamnosus GG with flaxseed mucilage using co–extrusion technique. J. Microencapsul. 2021, 38, 134–148. [Google Scholar] [CrossRef]
- Pang, R.; Mujuni, B.M.; Martinello, K.A.; Webb, E.L.; Nalwoga, A.; Ssekyewa, J.; Musoke, M.; Kurinczuk, J.J.; Sewegaba, M.; Cowan, F.M.; et al. Elevated serum IL–10 is associated with severity of neonatal encephalopathy and adverse early childhood outcomes. Pediatr. Res. 2022, 92, 180–189. [Google Scholar] [CrossRef]
- Sen, N.; Tanwar, S.; Jain, A.; Sharma, J.; Gokhroo, R.K.; Mehta, A.; Kalra, B. P6293 Assessment of testosterone/estradiol ratio, DHEA–S level and correlation with coronary inflammatory markers IL–1 & 6, TNF–1 and hsCRP predict 5 years risk of cardiovascular disease in men. Eur. Heart J. 2019, 40 (Suppl. S1), ehz746-0891. [Google Scholar]
- Cuellar–Núñez, M.L.; de Mejia, E.G.; Loarca–Piña, G. Moringa oleifera leaves alleviated inflammation through downregulation of il–2, il–6, and tnf–α in a colitis–associated colorectal cancer model. Food Res. Int. 2021, 144, 110318. [Google Scholar] [CrossRef] [PubMed]
- Sanchis, P.; Fernández–Gayol, O.; Comes, G.; Aguilar, K.; Escrig, A.; Giralt, M.; Palmiter, R.D.; Hidalgo, J. A new mouse model to study restoration of interleukin–6 (IL–6) expression in a Cre–dependent manner: Microglial IL–6 regulation of experimental autoimmune encephalomyelitis. J. Neuroinflamm. 2020, 17, 304. [Google Scholar] [CrossRef]
- Zhang, J.; Zhang, H.; Li, F.; Song, Z.; Li, Y.; Zhao, T. Identification of intestinal flora–related key genes and therapeutic drugs in colorectal cancer. BMC Med. Genom. 2020, 13, 172. [Google Scholar] [CrossRef] [PubMed]
- Wang, C.; Yan, D.; Huang, J.; Li, Y. Sprague–dawleyimpacts of changes in intestinal microbiota on the metabolism of rats. Bioengineered 2021, 12, 10603–10611. [Google Scholar] [CrossRef] [PubMed]
- Zhang, Y.; Li, T.; Yuan, H.; Pan, W.; Dai, Q. Correlations of inflammatory factors with intestinal flora and gastrointestinal incommensurate symptoms in children with asthma. Med. Sci. Monit. Int. Med. J. Exp. Clin. Res. 2018, 24, 7975–7979. [Google Scholar] [CrossRef] [PubMed]

| NO. | A | B | C | D | E | F | G |
|---|---|---|---|---|---|---|---|
| 1 | 0.60% | 6.0 | 1:6 | 1:5 | 1:2 | 40 min | 1.20% |
| 2 | 0.60% | 5.5 | 2:3 | 1:5 | 1:8 | 50 min | 1.00% |
| 3 | 0.30% | 5.5 | 1:4 | 1:10 | 1:6 | 30 min | 1.20% |
| 4 | 1.20% | 5.5 | 2:3 | 1:8 | 1:8 | 60 min | 0.60% |
| 5 | 0.90% | 5.5 | 1:8 | 1:20 | 1:2 | 60 min | 0.80% |
| 6 | 0.30% | 6.0 | 1:4 | 1:15 | 1:8 | 40 min | 1.00% |
| 7 | 0.90% | 6.0 | 1:4 | 1:20 | 1:8 | 30 min | 0.60% |
| 8 | 0.60% | 4.5 | 1:4 | 1:10 | 1:4 | 50 min | 0.80% |
| 9 | 1.20% | 5.0 | 1:8 | 1:5 | 1:6 | 30 min | 1.00% |
| 10 | 0.90% | 4.5 | 1:6 | 1:15 | 1:6 | 60 min | 1.00% |
| 11 | 0.30% | 5.5 | 1:8 | 1:15 | 1:2 | 50 min | 1.20% |
| 12 | 0.30% | 5.0 | 1:6 | 1:5 | 1:8 | 60 min | 0.80% |
| 13 | 1.20% | 4.5 | 1:4 | 1:5 | 1:4 | 60 min | 1.20% |
| 14 | 0.60% | 5.0 | 1:4 | 1:15 | 1:2 | 60 min | 0.60% |
| 15 | 0.90% | 6.0 | 1:8 | 1:5 | 1:4 | 50 min | 0.60% |
| 16 | 0.30% | 4.5 | 1:6 | 1:20 | 1:6 | 50 min | 0.60% |
| 17 | 0.90% | 4.5 | 2:3 | 1:10 | 1:2 | 40 min | 1.00% |
| 18 | 1.20% | 6.0 | 1:6 | 1:10 | 1:2 | 30 min | 0.80% |
| 19 | 0.30% | 5.0 | 2:3 | 1:20 | 1:4 | 40 min | 0.80% |
| 20 | 0.90% | 5.0 | 1:6 | 1:10 | 1:8 | 50 min | 1.20% |
| 21 | 1.20% | 6.0 | 2:3 | 1:15 | 1:6 | 50 min | 0.80% |
| 22 | 0.60% | 5.0 | 1:8 | 1:10 | 1:6 | 40 min | 0.60% |
| 23 | 0.90% | 5.5 | 1:4 | 1:5 | 1:6 | 40 min | 0.80% |
| 24 | 1.20% | 5.5 | 1:6 | 1:15 | 1:4 | 40 min | 0.60% |
| 25 | 1.20% | 4.5 | 1:4 | 1:10 | 1:4 | 40 min | 0.80% |
| 26 | 0.90% | 5.0 | 2:3 | 1:15 | 1:4 | 30 min | 1.20% |
| 27 | 0.60% | 6.0 | 2:3 | 1:20 | 1:6 | 60 min | 1.20% |
| 28 | 0.60% | 5.5 | 1:6 | 1:20 | 1:4 | 30 min | 1.00% |
| 29 | 0.30% | 4.5 | 2:3 | 1:5 | 1:2 | 30 min | 0.60% |
| 30 | 1.20% | 5.0 | 1:4 | 1:20 | 1:2 | 50 min | 1.00% |
| 31 | 0.30% | 6.0 | 1:8 | 1:10 | 1:4 | 60 min | 1.00% |
| 32 | 0.60% | 4.5 | 1:8 | 1:15 | 1:8 | 30 min | 0.80% |
| Name | Primer Sequence (5′–3′) |
|---|---|
| VP16srRNA–F | AGAGTTTGATCCTGGCTCAG |
| VP16srRNA–R | TACGGCTACCTTGTTACGACTT |
| tdh–F | GTAAAGGTCTCTGACTTTTGGAC |
| tdh–R | TGGAATAGAACCTTCATCTTCACC |
| tlh–R | AAAGCGGATTATGCAGAAGCACTG |
| tlh–F | GCTACTTTCTAGCATTTTCTCTGC |
| No. | EE (%) | No. | EE (%) | No. | EE (%) | No. | EE (%) |
|---|---|---|---|---|---|---|---|
| 1 | 58.83 ± 2.15 | 9 | 80.45 ± 0.76 | 17 | 81.90 ± 1.41 | 25 * | 93.12 ± 1.44 |
| 2 | 60.72 ± 1.16 | 10 | 65.75 ± 1.29 | 18 | 67.76 ± 0.72 | 26 | 65.78 ± 1.36 |
| 3 | 41.05 ± 0.39 | 11 | 72.81 ± 0.17 | 19 | 53.45 ± 0.48 | 27 | 42.15 ± 1.96 |
| 4 | 61.98 ± 1.04 | 12 | 67.54 ± 1.07 | 20 | 92.04 ± 1.06 | 28 | 56.84 ± 0.95 |
| 5 | 45.08 ± 0.92 | 13 | 58.22 ± 1.34 | 21 | 66.36 ± 0.59 | 29 | 72.89 ± 0.18 |
| 6 | 68.89 ± 0.84 | 14 | 75.99 ± 1.56 | 22 | 77.11 ± 1.01 | 30 | 74.12 ± 1.40 |
| 7 | 52.66 ± 0.57 | 15 | 62.02 ± 0.91 | 23 | 51.68 ± 2.06 | 31 | 56.77 ± 1.18 |
| 8 | 68.90 ± 0.66 | 16 | 61.13 ± 0.68 | 24 | 78.33 ± 0.74 | 32 | 67.48 ± 0.78 |
| 107 CFU/mL | 108 CFU/mL | 109 CFU/mL | |
|---|---|---|---|
| Size of inhibition zone (mm) | 1.58 ± 0.23 | 15.16 ± 0.32 | 20.12 ± 0.22 |
| sensitivity | low–alcohol sensitivity | medium sensitivity | highly sensitivity |
| Day | Groups | |||||
|---|---|---|---|---|---|---|
| YL | WN | KJT | 6 h | 9 h | Negative | |
| 1 | 3.22 ± 0.13 | 3.90 ± 0.03 | 3.52 ± 0.08 | 3.17 ± 0.06 | 3.08 ± 0.06 | 4.74 ± 0.13 |
| 9 | 4.14 ± 0.09 | 4.89 ± 0.30 | 4.39 ± 0.11 | 5.05 ± 0.08 | 4.82 ± 0.09 | 4.93 ± 0.11 |
| Day | Groups | ||||||
|---|---|---|---|---|---|---|---|
| YL (pg/mL) | WN (pg/mL) | KJT (pg/mL) | 6 h (pg/mL) | 9 h (pg/mL) | Positive (pg/mL) | Negative (pg/mL) | |
| A1 | 115.44 ± 4.61 | 157.68 ± 9.54 | 172.02 ± 4.01 | 120.51 ± 5.22 | 157.65 ± 7.97 | 181.85 ± 2.67 | 69.32 ± 3.5 |
| A2 | 106 ± 4.31 | 114.64 ± 4.54 | 108.14 ± 2.69 | 96.27 ± 2 | 107.55 ± 2.48 | 167.51 ± 2.82 | 62.35 ± 4.25 |
| A3 | 95.61 ± 4.49 | 92.07 ± 6.08 | 88.83 ± 2.38 | 83.69 ± 2.71 | 101.13 ± 1.62 | 157.38 ± 2.64 | 61.9 ± 4.15 |
| A6 | 82.41 ± 2.58 | 82.97 ± 2.28 | 83.44 ± 4.15 | 76.14 ± 1.64 | 82.06 ± 1.68 | 169.1 ± 1.39 | 64.72 ± 2.46 |
| A10 | 71.85 ± 1.52 | 69.66 ± 3.4 | 73.95 ± 3.1 | 69.54 ± 3.02 | 68.07 ± 2.76 | 109.6 ± 7.31 | 65.54 ± 1.65 |
| B1 | 285.15 ± 9.68 | 263.31 ± 7.34 | 284.92 ± 9.99 | 252.93 ± 23.09 | 358.06 ± 9.6 | 217.03 ± 8.19 | 44.41 ± 5.72 |
| B2 | 191.07 ± 6.04 | 158.29 ± 11.82 | 191.94 ± 6.13 | 109.04 ± 1.73 | 178.16 ± 10.6 | 362.14 ± 20.9 | 45.54 ± 4.49 |
| B3 | 192.18 ± 4.8 | 110.17 ± 7.04 | 151.47 ± 3 | 91.96 ± 4.13 | 82.13 ± 1.52 | 284.62 ± 6.03 | 47.83 ± 3.97 |
| B6 | 114.86 ± 9.48 | 90.54 ± 2.24 | 115.47 ± 5.5 | 78.34 ± 2.73 | 71.88 ± 1.74 | 247.95 ± 12.98 | 48.82 ± 1.19 |
| B10 | 70.59 ± 6.47 | 46.73 ± 5.06 | 64.56 ± 5.2 | 54.26 ± 3.47 | 47.11 ± 3.77 | 116.05 ± 6.8 | 40.32 ± 2.89 |
| C1 | 58.35 ± 2.28 | 66.91 ± 2.43 | 62.17 ± 5.14 | 47.63 ± 3.56 | 61.71 ± 2.73 | 42.61 ± 2.73 | 13.26 ± 1.01 |
| C2 | 31.78 ± 2.48 | 27.29 ± 2.06 | 44.43 ± 0.99 | 30.29 ± 2.01 | 31.62 ± 1.14 | 53.42 ± 9.14 | 11.29 ± 0.82 |
| C3 | 27.47 ± 2.9 | 23.41 ± 1.28 | 21.79 ± 4.5 | 17.02 ± 2.03 | 14.6 ± 2.48 | 50.68 ± 5.14 | 10.22 ± 0.82 |
| C6 | 33.33 ± 0.8 | 11.48 ± 1.03 | 16.38 ± 3.7 | 13.25 ± 1.81 | 12.22 ± 1.22 | 31.06 ± 7.1 | 12.64 ± 0.92 |
| C10 | 18.11 ± 0.68 | 11.17 ± 0.07 | 15.77 ± 0.5 | 11.94 ± 1.55 | 10.63 ± 1.37 | 31.98 ± 10.01 | 13.89 ± 1.43 |
| D1 | 160.28 ± 14.3 | 151.04 ± 6.31 | 187.16 ± 8.53 | 130.54 ± 5.65 | 146.56 ± 6.14 | 199.45 ± 4.45 | 41.36 ± 0.86 |
| D2 | 93.68 ± 4.26 | 75.36 ± 2.86 | 152.84 ± 3.58 | 89.21 ± 9.06 | 133.54 ± 3.7 | 227.38 ± 61.01 | 38.03 ± 1.9 |
| D3 | 73.74 ± 4.33 | 60.36 ± 2.10 | 68.01 ± 2.16 | 62.06 ± 2.98 | 71.4 ± 2.24 | 115.89 ± 7.73 | 36.86 ± 1.14 |
| D6 | 62.4 ± 1.14 | 47.66 ± 1.17 | 66.13 ± 1.57 | 53.49 ± 2.73 | 66.45 ± 2.35 | 84.35 ± 5.12 | 39.08 ± 3.02 |
| D10 | 53.13 ± 3.09 | 34.10 ± 0.96 | 52.87 ± 2.6 | 40.65 ± 4.3 | 39.63 ± 2.59 | 82.77 ± 2 | 37.12 ± 4.05 |
| Day | Groups | |||||
|---|---|---|---|---|---|---|
| YL lg (CFU/g) | WN lg (CFU/g) | KJT lg (CFU/g) | 6 h lg (CFU/g) | 9 h lg (CFU/g) | Negative lg(CFU/g) | |
| 1 | 7.47 ± 0.28 | 6.9 ± 0.14 | 7.65 ± 0.11 | 7.34 ± 0.22 | 8.67 ± 0.51 | 0 |
| 2 | 6.85 ± 0.34 | 5.73 ± 0.24 | 7.31 ± 0.39 | 6.44 ± 0.26 | 7.45 ± 0.28 | 0 |
| 3 | 6.73 ± 0.29 | 5.69 ± 0.08 | 5.64 ± 0.31 | 2.42 ± 0.41 | 5.65 ± 0.32 | 0 |
| 4 | 5.36 ± 0.48 | 2.12 ± 0.18 | 1.34 ± 0.15 | 0 | 1.09 ± 0.03 | 0 |
| 5 | 2.05 ± 0.14 | 0 | 0 | 0 | 0 | 0 |
| 6 | 0 | 0 | 0 | 0 | 0 | 0 |
| Sample | Barcode | SeqNum | BaseNum | MeanLen | MinLen | MaxLen |
|---|---|---|---|---|---|---|
| WN–1 | TTCCAT | 89669 | 37107766 | 413.83 | 361 | 467 |
| YL–1 | TCCTGT | 49005 | 20653859 | 421.46 | 358 | 463 |
| KJT–1 | GAAGGC | 45220 | 18915799 | 418.31 | 388 | 465 |
| 6 h–1 | ATGTCA | 58962 | 24649490 | 418.06 | 354 | 461 |
| 9 h–1 | CGGTTA | 70867 | 29535906 | 416.78 | 362 | 465 |
| WN–9 | CTATAC | 91653 | 38183432 | 416.61 | 358 | 443 |
| YL–9 | AGGAAC | 60873 | 25518039 | 419.2 | 357 | 470 |
| KJT–9 | TTGCTC | 45663 | 18968502 | 415.4 | 357 | 472 |
| 6 h–9 | TGCTTA | 40792 | 17076309 | 418.62 | 356 | 446 |
| 9 h–9 | AGTGGC | 44446 | 18704699 | 420.84 | 368 | 467 |
| negative | TATTCT | 64246 | 27004824 | 420.33 | 373 | 460 |
| positive | AGAGTA | 72845 | 30729200 | 421.84 | 362 | 476 |
| Sample | Shannon | Chao | ACE | Simpson | Shannoneven | Coverage |
|---|---|---|---|---|---|---|
| 6 h–1 | 2.622829 | 220.05 | 213.0943 | 0.163929 | 0.503472 | 0.999063 |
| 6 h–9 | 2.954129 | 256 | 262.5695 | 0.114476 | 0.546335 | 0.998562 |
| 9 h–1 | 1.923763 | 207.3704 | 215.237 | 0.277893 | 0.371659 | 0.999251 |
| 9 h–9 | 2.176321 | 201 | 211.22 | 0.190497 | 0.417761 | 0.998963 |
| KJT–1 | 2.255237 | 238.6667 | 221.9981 | 0.201234 | 0.436175 | 0.998695 |
| KJT–9 | 2.95379 | 269.25 | 261.0984 | 0.118612 | 0.54019 | 0.998802 |
| WN–1 | 1.939884 | 236.4286 | 236.5196 | 0.383198 | 0.359966 | 0.999557 |
| WN–9 | 3.75668 | 264.0526 | 265.6699 | 0.048502 | 0.677468 | 0.999689 |
| YL–1 | 3.018849 | 239.2759 | 244.2592 | 0.081175 | 0.564075 | 0.998813 |
| YL–9 | 2.922499 | 256.6207 | 255.9447 | 0.112485 | 0.527034 | 0.998911 |
| negative | 2.591384 | 255.4545 | 245.243 | 0.145064 | 0.488179 | 0.998855 |
| positive | 2.745618 | 182.7143 | 182.6732 | 0.104154 | 0.537094 | 0.999385 |
Publisher’s Note: MDPI stays neutral with regard to jurisdictional claims in published maps and institutional affiliations. |
© 2022 by the authors. Licensee MDPI, Basel, Switzerland. This article is an open access article distributed under the terms and conditions of the Creative Commons Attribution (CC BY) license (https://creativecommons.org/licenses/by/4.0/).
Share and Cite
Zhou, T.; Liu, M.; Pan, J.; Ren, J.; Tang, F.; Dai, J.; Xue, F.; Ji, D. Combined Therapy of Probiotic Microcapsules and Bomidin in Vibrio parahaemolyticus–Infected Rats. Life 2022, 12, 1740. https://doi.org/10.3390/life12111740
Zhou T, Liu M, Pan J, Ren J, Tang F, Dai J, Xue F, Ji D. Combined Therapy of Probiotic Microcapsules and Bomidin in Vibrio parahaemolyticus–Infected Rats. Life. 2022; 12(11):1740. https://doi.org/10.3390/life12111740
Chicago/Turabian StyleZhou, Ting, Mengting Liu, Jialiang Pan, Jianluan Ren, Fang Tang, Jianjun Dai, Feng Xue, and Dejun Ji. 2022. "Combined Therapy of Probiotic Microcapsules and Bomidin in Vibrio parahaemolyticus–Infected Rats" Life 12, no. 11: 1740. https://doi.org/10.3390/life12111740
APA StyleZhou, T., Liu, M., Pan, J., Ren, J., Tang, F., Dai, J., Xue, F., & Ji, D. (2022). Combined Therapy of Probiotic Microcapsules and Bomidin in Vibrio parahaemolyticus–Infected Rats. Life, 12(11), 1740. https://doi.org/10.3390/life12111740
